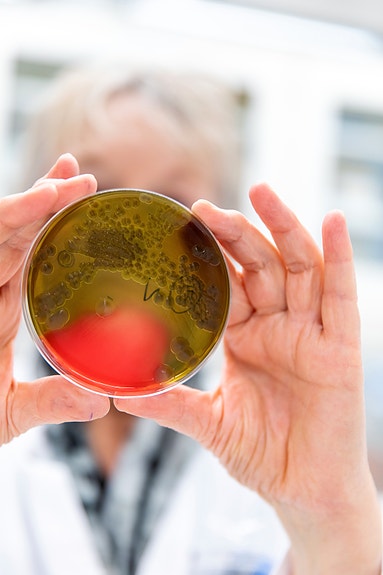
Bilde 2 av 3 i jobbannonse-galleriet

Seksjonsleder - forskning akvatisk biosikkerhet
Veterinærinstituttet
- Frist 08.08.2025
- Ansettelsesform Fast
Seksjonsleder - Forskning akvatisk biosikkerhet
Om stillingen
Ønsker du å lede og videreutvikle vårt arbeid innen fiskehelse og biosikkerhet?
Veterinærinstituttet har en viktig rolle i samfunnet innen diagnostikk, overvåkning, beredskap og forskning. For å styrke og videreutvikle kunnskap om helsetrusler mot fisk i oppdrett og i naturen, søker vi nå en trygg og fremtidsrettet leder til seksjon Forskning akvatisk biosikkerhet med kontorsted Bergen.
Seksjonen har for tiden 19 ansatte, med arbeidsted Bergen og Ås, og har et bredt spekter av oppgaver innenfor biosikkerhet, patogeneseforskning, histopatologi og mikrobiologi, og inkluderer det nye fagfeltet helseøkonomi. Seksjonen har også ansvar for drift av det regionale laboratoriet i Bergen, med spesialkompetanse innen fiskebakteriologi. Som seksjonsleder får du ansvar for en seksjon med høyt kompetansenivå, faglig engasjement og stort potensial.
Veterinærinstituttet videreutvikler sin organisasjon, noe som kan medføre justeringer i avdelingens og seksjonens ansvarsområder og oppgaver.
Du er velkommen til å ta kontakt med avdelingsdirektør Ingunn Sommerset - tlf. 92 61 63 60.
Hva går jobben ut på?
Strategisk og effektiv ledelse er avgjørende for Veterinærinstituttet, og vi søker en leder som kan drive seksjonen fremover med tydelig retning og samtidig ha god dialog og være samspillende på tvers i organisasjonen. Seksjonen spiller en viktig rolle i samspillet mellom næring, forvaltning og forskning, men har også medarbeidere som bidrar til diagnostikk og beredskap. Som seksjonsleder må du og dine medarbeidere fremme god dialog, effektiv arbeidsdeling og god rolleforståelse internt og eksternt.
Du vil være en del ledergruppen til Avdeling for fiskehelse og -velferd og inngå i Veterinærinstituttets utvidede ledergruppe. Stillingen krever at du håndterer et bredt spekter av oppgaver og identifiserer deg med instituttets lederprinsipper: tilgjengelig, utviklende, tydelig og ansvarlig.
Vi ser etter en leder som kombinerer sterke faglige kvalifikasjoner med god medarbeideroppfølging. Du vil ha personalansvar for seksjonens ansatte (forskere og ingeniører), du skal sikre god ressursstyring og du motiverer og utvikler teamet ditt.
Det forventes noe reising i stillingen, hovedsakelig mellom Bergen og Ås.
Hvilke kvalifikasjoner er viktige i jobben?
For å lykkes i denne stillingen må du ha relevant ledererfaring og interesse for personal- og strategisk ledelse. Du må være utdannet minimum på mastergradsnivå innenfor seksjonens fagfelt, og ha kunnskap om norsk akvakultur og offentlig forvaltning. Stillingen krever også at du har god skriftlig og muntlig fremstillingsevne på norsk eller et annet skandinavisk språk, samt engelsk.
I tillegg ønsker vi at du har doktorgrad innenfor sykdomsrelatert forskning, og at du har et godt nasjonalt og internasjonalt faglig nettverk.
Hvilke personlige egenskaper ser vi etter hos deg?
Vi søker deg som er:
- trygg, tydelig og ansvarlig i din rolleutøvelse
- kommuniserende og inkluderende og som bidrar til godt samarbeid og samhandling
- fremoverlent, løsningsorientert med god gjennomføringsevne
- opptatt av å utvikle både egne medarbeidere og Veterinærinstituttet som helhet
Du må kunne identifisere deg med Veterinærinstituttets verdier: Fremtidsrettet, faglig ambisiøs og samspillende.
Vi tilbyr
- en viktig rolle med stor grad av selvstendighet og påvirkningsmuligheter
- et fagsterkt kompetansemiljø som gir muligheter for egen læring og utvikling
- en variert og allsidig hverdag
- gode arbeidstidsordninger med fleksitid og sommertid, og mulighet til å trene litt i arbeidstiden
- mulighet for delvis bruk av hjemmekontor etter avtale
Du blir medlem av Statens Pensjonskasse, med gode pensjons- og forsikringsordninger, og med mulighet for å søke om boliglån med gunstige betingelser. Les mer på spk.no. Det blir trukket 2 % av lønna for dette innskuddet. Stillingen lønnes etter Statens lønnsregulativ, og du blir ansatt som seksjonsleder i stillingskode 1211. Lønnsplasseringen avhenger av kvalifikasjonene dine.
Hvordan søker du?
Hvis du finner ovennevnte av interesse, gleder vi oss til å se din søknad. CV, vitnemål, attester og øvrige relevante dokumenter lastes opp i vår elektroniske portal hos Jobbnorge.
Når du søker på stillingen, ber vi deg hente utdanningsresultatene dine fra Vitnemålsportalen.no. Om utdanningsresultatene dine ikke er tilgjengelige via Vitnemålsportalen, ber vi deg laste opp kopier av vitnemålene eller karakterutskriftene dine. All dokumentasjon må være på norsk, eventuelt et annet skandinavisk språk eller engelsk.
Veterinærinstituttet er en statlig virksomhet, og i henhold til offentlighetsloven blir alle søkere satt på en offentlig søkerliste etter søknadsfristens utløp. Søknad om unntak fra offentlig søkerliste kan gis i særskilte tilfeller. Om søknaden om unntak ikke blir tatt til følge, blir du kontaktet. Da må du ta stilling til om du ønsker å bli unntatt fra den offentlige søkerlisten og du må begrunne hvorfor. Vi tar kontakt med deg dersom vi ikke tar ønsket ditt til følge, og du vil da få mulighet til å trekke søknaden din.
Veterinærinstituttet verdsetter mangfold
Våre medarbeidere har ulik bakgrunn når det gjelder nasjonalitet, utdanning, arbeidserfaring og livserfaring - noe vi ser på som en styrke. Vi tror at ulike perspektiver bidrar til bedre løsninger og et mer inkluderende arbeidsmiljø.
Vi følger statlige retningslinjer for inkluderende rekruttering. Kvalifiserte søkere med funksjonsnedsettelse, hull i CV-en eller innvandrerbakgrunn vil bli invitert til intervju dersom vilkårene er oppfylt. Vi oppfordrer deg derfor til å krysse av for dette når du søker stillingen hos oss.
FerdigheterAI-generert
- Administrere ressurser
- Akvakultur
- Bakteriologi
- Biosikkerhet
- Mikrobiologi
- Offentlig administrasjon og forvaltning
JobbMatch
BetaEr du kvalifisert for jobben?
Nysgjerrig på om du kvalifiserer til denne jobben? Med JobbMatch får du umiddelbar tilbakemelding på hvor godt din profil matcher stillingsutlysningen.
Om arbeidsgiveren
Veterinærinstituttet er et forvaltningsorgan med særskilt fullmakt under Landbruks- og matdepartementet. Faglig og økonomisk sorterer Veterinærinstituttet både under Landbruks- og matdepartementet og Nærings- og fiskeridepartementet.
Vår oppgave er å avdekke og avverger smittsomme sykdommer, og kjente og ukjente trusler mot helsen til dyr, mennesker og miljø. Sammen med myndigheter, næringsliv og andre kunnskapsmiljø øker vi kunnskapen for å sikre god dyrehelse og dyrevelferd, trygg mat og bærekraftige bionæringer.
Veterinærinstituttet er utnevnt som nasjonalt referanselaboratorium på over 30 fagområder og som internasjonalt referansesenter for Verdens dyrehelseorganisasjon (WOAH) på flere områder.
Vår visjon "God helse hos dyr og mennesker" skal nås gjennom tydelige mål og et strategisk, faglig samarbeide med partnere i over 40 land i tillegg til Norge. Instituttet har rundt 330 ansatte, fordelt på våre lokasjoner i Tromsø, Harstad, Trondheim, Bergen, Sandnes og på hovedkontoret på Ås i Akershus.
- Sektor: Offentlig
- Sted: Thormøhlens gate 53C, 5006 Bergen
- Bransje: Forskning, utdanning og vitenskap, Offentlig administrasjon
- Stillingsfunksjon: Forskning/Stipendiat/Postdoktor, Ledelse
(1/3)
Annonseinformasjon
- FINN-kode 414215281
- Sist endret